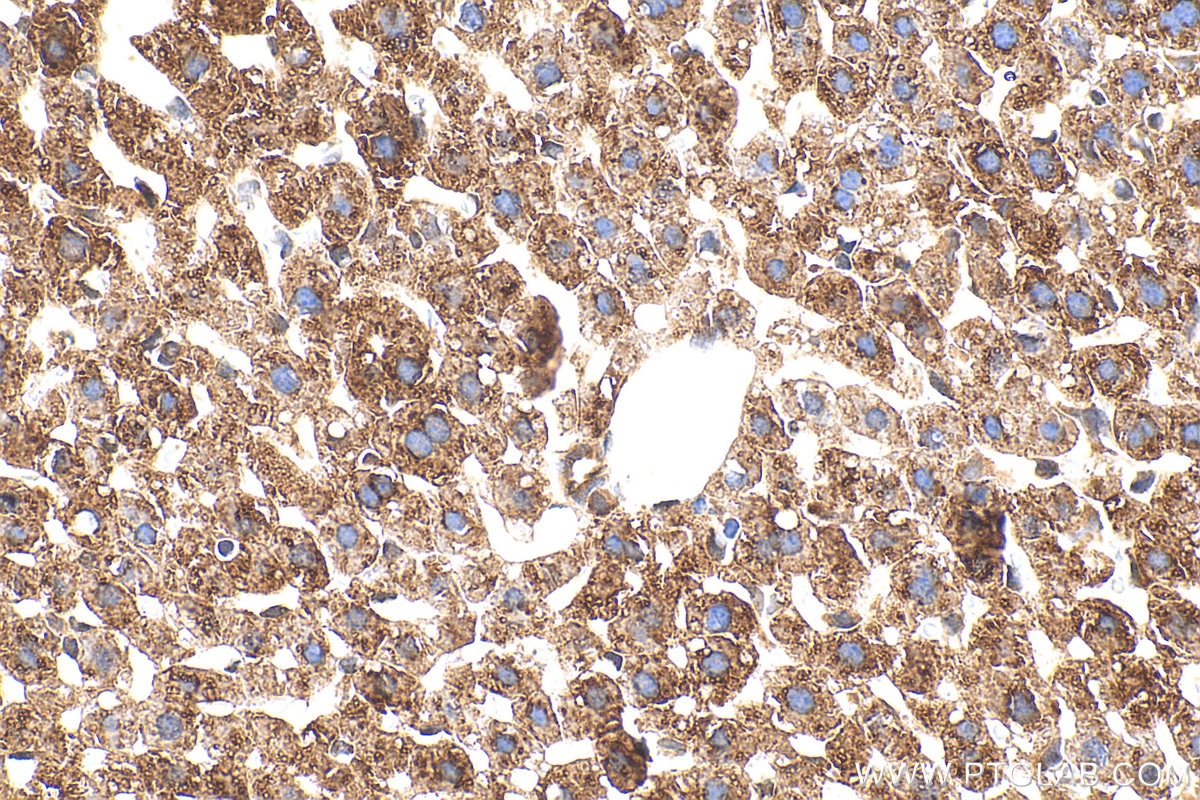
Immunohistochemistry (IHC) staining of mouse liver tissue using AWAT1 Polyclonal antibody (24704-1-AP)

Tested Applications
| Positive WB detected in | HEK-293 cells, 3T3-L1 cells, NIH/3T3 cells |
| Positive IHC detected in | mouse liver tissue Note: suggested antigen retrieval with TE buffer pH 9.0; (*) Alternatively, antigen retrieval may be performed with citrate buffer pH 6.0 |
Recommended dilution
| Application | Dilution |
|---|---|
| Western Blot (WB) | WB : 1:500-1:2000 |
| Immunohistochemistry (IHC) | IHC : 1:50-1:500 |
| It is recommended that this reagent should be titrated in each testing system to obtain optimal results. | |
| Sample-dependent, Check data in validation data gallery. | |
Product Information
24704-1-AP targets AWAT1 in WB, IHC, ELISA applications and shows reactivity with human, mouse samples.
| Tested Reactivity | human, mouse |
| Host / Isotype | Rabbit / IgG |
| Class | Polyclonal |
| Type | Antibody |
| Immunogen |
CatNo: Ag20183 Product name: Recombinant human AWAT1 protein Source: e coli.-derived, PGEX-4T Tag: GST Domain: 134-195 aa of BC153034 Sequence: LATLSWFFKIPFVREYLMAKGVCSVSQPAINYLLSHGTGNLVGIVVGGVGEALQSVPNTTTL Predict reactive species |
| Full Name | acyl-CoA wax alcohol acyltransferase 1 |
| Calculated Molecular Weight | 328 aa, 38 kDa |
| Observed Molecular Weight | 45 kDa |
| GenBank Accession Number | BC153034 |
| Gene Symbol | AWAT1 |
| Gene ID (NCBI) | 158833 |
| Conjugate | Unconjugated |
| Form | Liquid |
| Purification Method | Antigen affinity purification |
| UNIPROT ID | Q58HT5 |
| Storage Buffer | PBS with 0.02% sodium azide and 50% glycerol, pH 7.3. |
| Storage Conditions | Store at -20°C. Stable for one year after shipment. Aliquoting is unnecessary for -20oC storage. 20ul sizes contain 0.1% BSA. |
Background Information
AWAT1 is an ER-localized acyltransferase specialized for wax ester biosynthesis in sebaceous and meibomian glands. By esterifying long-chain fatty acyl-CoAs with fatty alcohols, AWAT1 generates crucial lipids that maintain skin barrier function, sebaceous secretion, and tear film stability. Dysregulation of AWAT1 contributes to meibomian gland dysfunction, dry eye disease, and sebaceous lipid imbalance, positioning AWAT1 as a key enzymatic regulator of surface lipid homeostasis.
Protocols
| Product Specific Protocols | |
|---|---|
| IHC protocol for AWAT1 antibody 24704-1-AP | Download protocol |
| WB protocol for AWAT1 antibody 24704-1-AP | Download protocol |
| Standard Protocols | |
|---|---|
| Click here to view our Standard Protocols |